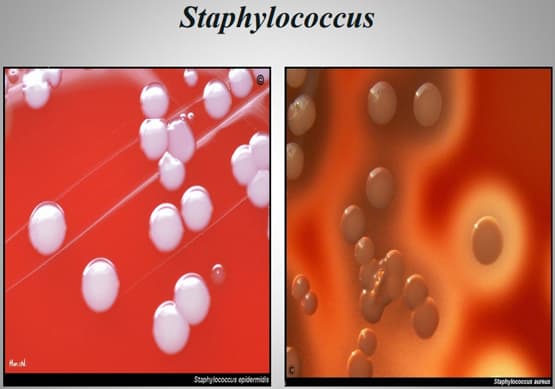

Importancia de los cultivos bacteriológicos en el diagnóstico de la mastitis bovina y antibiograma
Publicado: 21 de agosto de 2019
Fuente: Dra. Martha Alicia Castañeda Vazquez, Dr. Hugo Castañeda Vazquez, Biol. Erika P. Salas C. M.C. Carlos Bedolla Cedeño
Importancia en el valor higiénico de la leche y de sus subproductos.
- Algunos agentes causales de Mastitis son patógenos en humanos.
- Puede haber residuos de antibióticos o químicos en la leche por el tratamiento de la ubre.
- Perdidas para el ganadero; por disminución en la producción de leche, costos en el tratamiento y/o eliminación del animal.
- Para la industria de lácteos; transformaciones causadas a la leche y sus subproductos por la mastitis (el tiempo de cuajado aumenta y la cantidad de queso disminuye)
Perdidas causadas por mastitis clínica
- Baja producción del animal enfermo.
- Perdida de producción por la duración de la eliminación del medicamento.
- Costos de medicamentos y del Médico Veterinario.
- Aumento en los costos de la mano de obra.

Perdidas causadas por mastitis subclínica
- Reducción en la producción diaria de leche.
- Cambios en la composición de la leche.
- Disminución en el valor higiénico de la leche



METODOS DE INVESTIGACION
- Pba. de California
- Conteo celulas somáticas
- Examen bacteriologico
- Antibiogramas

CULTIVOS BACTERIOLÓGICOS
- Aislamiento e identificación del agente patógeno
- Factores de patogenicidad
- Resistencia bacteriana
- Tratamiento
- Medidas de prevención










TINCIONES
- Gram; morfología bacteriana
- Ziehl Neelsen; para bacterias acido-alcohol resistentes
- Schaeffer Fulton; esporas
- Azul de metileno; flagelos
- Tinta china; esporas


ANTIBIOGRAMA
Método para la determinación del espectro de susceptibilidad o resistencia de un microorganismo a diversos antimicrobianos.
Permiten al clínico hacer una elección del tratamiento más apropiado.
Permite seguir la evolución de las resistencias bacterianas (seguimiento epidemiológico).
PRUEBAS DE SENSIBILIDAD BACTERIANA IN VITRO
Método de dilución en caldo (macrodilución y microdilución)
Método de dilución del antibiótico en agar
Método de difusión del antibiótico en agar (Kirby-Bauer)
E-Test (Epsilon Test)
Métodos automatizados (MicroScan)




Un hato lechero puede ser declarado con seguridad como libre de bacterias, cuando en los últimos muestreos se observa que en ninguna de las muestras de leche del inicio del ordeño de los cuartos, existe la presencia de bacterias.
Contenido del evento:
Temas relacionados:
Autores:

Referentes que Recomendaron :
Hugo Castañeda VázquezRecomendar
Comentar
Compartir
Recomendar
Responder
Recomendar
Responder
Recomendar
Responder
5 de septiembre de 2019
Buenos días:
La causa podría ser uso de alimentación concentrado?, de preferencia que insumo ?
Muchas gracias
Recomendar
Responder
Qualtia Alimentos
4 de septiembre de 2019
Excelente información, felicidades! y gracias por compartir.
Recomendar
Responder

¿Quieres comentar sobre otro tema? Crea una nueva publicación para dialogar con expertos de la comunidad.